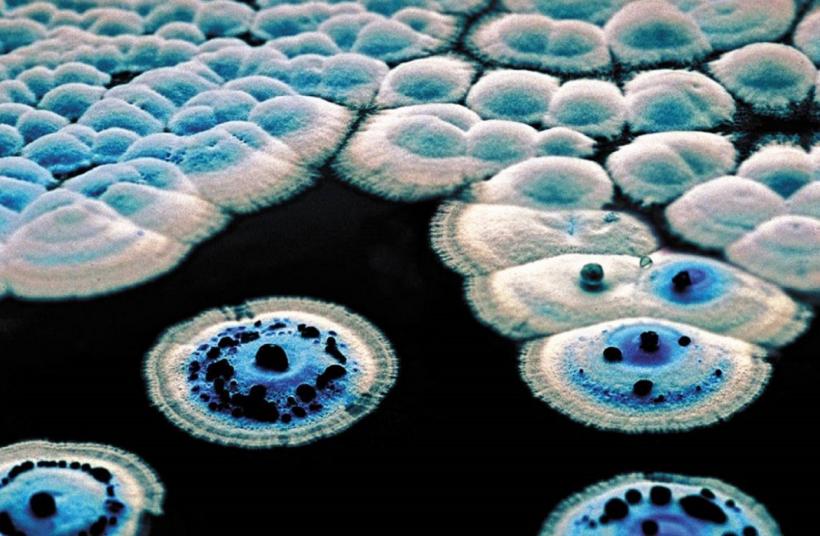
Antibioticul „ascuns la vedere” timp de șapte decenii, capabil să învingă superbacteriile

Un nou antibiotic puternic, capabil să combată unele dintre cele mai periculoase bacterii rezistente la medicamente, printre care și temutul Stafilococ auriu rezistent la meticilină (MRSA), a fost descoperit recent de o echipă de cercetători din Marea Britanie şi Australia. Surpriza oamenilor de știință a fost că noul compus, care în teste s-a dovedit incomparabil mai eficient decât alte antimicrobiene uzuale, se formează în mod natural în procesul de sinteză al unui alt antibiotic studiat intens de mai bine de jumătate de secol, dar nu a fost observat anterior.
Rezistența antimicrobiană reprezintă o amenințare tot mai mare pentru sănătatea publică, avertiza recent Organizația Mondială a Sănătății (OMS), care, în urma analizării datelor raportate din peste 100 de țări către Sistemul Global de Supraveghere a Rezistenței la Antimicrobiene și a Utilizării acestora (GLASS), a identificat o creștere alarmantă la nivel mondial a infecțiilor care nu mai răspund la tratamentele standard.
Concret, în prezent, una din șase infecții bacteriene comune nu mai răspunde la tratamentul cu antibiotic, conform ultimului raport al OMS, publicat luna trecută, când agenția pentru Sănătate a ONU a avertizat că progresele medicinei moderne nu mai reușesc să țină pasul cu superbacteriile, care devin tot mai periculoase de la un an la altul, în timp ce, în lipsa unor stimulente comerciale, care descurajează investițiile în descoperirea de antibiotice, există „prea puține antibacteriene în pregătire”.
Într-un nou studiu, publicat săptămâna trecută în Journal of the American Chemical Society (JACS), chimiștii de la Universitatea din Warwick (Marea Britanie) şi Universitatea Monash (Australia) arată că au identificat un nou antibiotic foarte promițător, numit pre-metilenomicină C lactonă, acolo unde se așteptau mai puțin.
Compus intermediar în procesul de producere a altui antibiotic
„Noul antibiotic a fost găsit «ascuns la vedere» ca o substanță chimică intermediară în procesul natural care produce binecunoscutul antibiotic metilenomicina A”, a transmis, într-un comunicat de presă, Universitatea din Warwick.
Mai exact, echipa a identificat un compus derivat dintr-un microorganism din genul Streptomyces, cunoscut pentru capacitatea de a produce antibiotice.
„Metilenomicina A a fost descoperită inițial în urmă cu 50 de ani și, deși a fost sintetizată de mai multe ori, nimeni nu pare să fi testat intermediarii sintetici pentru activitatea antimicrobiană! Prin ștergerea genelor biosintetice, am descoperit doi intermediari biosintetici necunoscuți anterior, ambii fiind antibiotice mult mai puternice decât metilenomicina A în sine”, a explicat profesorul Greg Challis, unul dintre autorii principali ai studiului.
În testele de laborator, pre-metilenomicina C lactona, unul dintre cei doi compuși intermediari, „s-a dovedit a fi de peste 100 de ori mai activ” decât antibioticul original metilenomicina A împotriva diferitelor bacterii Gram-pozitive, categoria de bacterii care dezvoltă tot mai frecvent rezistenţă la tratamentele actuale.
„Mai exact, s-a dovedit a fi eficient împotriva S. aureus și E. faecium, specia bacteriană din spatele Staphylococcus aureus rezistent la meticilină (MRSA) și, respectiv, a enterococului rezistent la vancomicină (VRE)”, conform comunicatului universității britanice. Practic, este vorba despre două dintre cele mai dificile infecţii de tratat în prezent.
„A fost o adevărată surpriză”
„Este remarcabil că bacteria care produce metilenomicina A și pre-metilenomicina C lactonă – Streptomyces coelicolor – este o specie-model producătoare de antibiotice care a fost studiată pe larg încă din anii 1950. Găsirea unui nou antibiotic într-un organism atât de familiar a fost o adevărată surpriză”, a declarat Lona Alkhalaf, cercetător chimist la Universitatea Warwick și coautoare a studiului.
Un aspect important al cercetării este că oamenii de știință nu au detectat nicio rezistență la noul antibiotic în bacteriile Enterococcus în condiții în care se observă rezistență la vancomicină (tratamentul de „ultimă linie” pentru infecția cu Enterococcus), astfel încât această descoperire este deosebit de promițătoare pentru VRE.
Această caracteristică este extrem de valoroasă în contextul actual, în care rezistenţa antimicrobiană provoacă milioane de decese, la nivel global, în fiecare an.
O nouă direcţie în descoperirea antibioticelor
Autorii studiului consideră că această abordare marchează o nouă direcţie în descoperirea antibioticelor. Mai exact, prin analiza intermediarilor chimici din sinteza antibioticelor naturale existente, s-ar putea identifica alte molecule cu potenţial terapeutic ridicat şi cu o probabilitate mult mai mică de a genera rezistenţă la tratament.
Următorul pas în dezvoltarea antibioticului va fi testarea acestuia în studii preclinice.
Cu structura sa simplă, acțiunea puternică și profilul care nu determină rezistența antimicrobiană, „lactona pre-metilenomicină C reprezintă un nou candidat promițător care ar putea ajuta la salvarea unora dintre cei 1,1 milioane de oameni care sunt victime ale RAM în fiecare an”, conchid autorii cercetării.